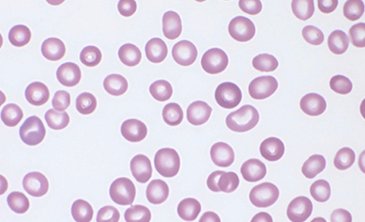

- Biologia molekularna
- Diagnostyka
- Biologia komórki
- Formularz reklamacyjny
- Biobank
-
Kategorie produktów
- ProZyme
- Młynki
- Materialy ogólnolaboratoryjne
- Wzorce i materiały odniesienia Agilent Technologies
- Przygotowanie próbki
- Dozowanie cieczy
- Akcesoria do chromatografii cieczowej
- Akcesoria do chromatografii gazowej
- Akcesoria do spektroskopii
- Akcesoria do Dissolution
- CrossLab
- Materiały do analizy mikotoksyn
- Wzorce i certyfikowane materiały odniesienia
- Termodesorpcja
- Drobny sprzęt laboratoryjny
- Laboratoryjne systemy oczyszczania wody
- Wiskozymetry
- Reometry
- Analizatory tekstury
- Analizatory wilgotności
- Analizator płynięcia proszków
- Producenci
- Oferty i nowości
- Formularz reklamacyjny